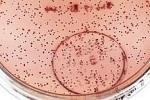
Бактерии могут «прятаться»

Тег: Прятаться

31 марта 2014, 16:39
В Невинномысске грабитель мебельного пытался спрятаться от полицейских на кровати
30 марта в одном из мебельных салонов Невинномысска сработала сигнализация. На место происшествия оперативно прибыли сотрудники патрульно-постовой слу...
15 декабря 2011, 07:30
Бактерии могут «прятаться»
В экстремальных критериях бактерии сводят процессы собственной жизнедеятельности к минимуму. Так им удается «спрятаться», чтоб не быть найденными. Киш...

10 августа 2010, 08:41
Минобороны учит новобранцев прятаться от обидчиков и заниматься самовнушением
Страдающим от дедовщины солдатам, Министерство обороны советует заняться самовнушением, или в крайнем случае – прятаться. Но только на территории воин...